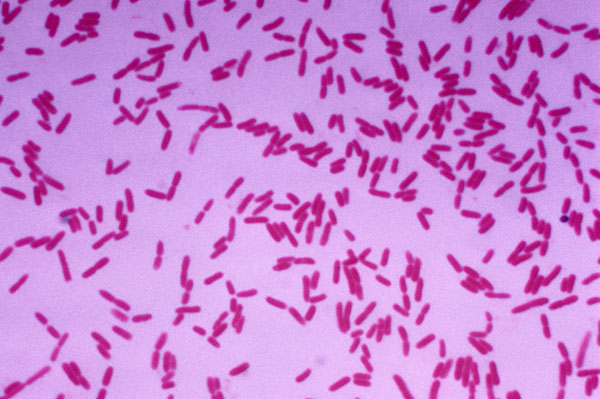

夏季對于羅氏沼蝦而言是其生長的黃金時期,然而這一季節也是水產養殖風險*為集中的時段。持續的高溫*易導致水溫飆升、水質急劇惡化和溶氧不足,從而給養殖戶帶來不小的經濟損失。為了助力廣大羅氏沼蝦養殖戶安然度過這一風險期,以下是一些關鍵的應對措施和管理要點。

一、科學投喂,助力健康成長
在高溫季節,羅氏沼蝦進入快速生長期,它們對飼料的需求也更為旺盛。此時選擇適口性好、營養均衡的優質飼料至關重要。投喂時要堅持科學、精準的原則,既要確保蝦能夠攝取足夠的營養,又要避免過量投喂造成的飼料浪費和水質污染。
為了進一步提升羅氏沼蝦的腸道健康和生長速度,養殖戶可以在飼料中適當添加乳酸菌等益生菌。這些益生菌不僅能夠維護蝦的腸道微生態平衡,還能提高其對飼料的消化吸收能力。此外,拌入免疫多糖和維生素等添加劑,也能有效增強蝦的免疫力和抗病能力。
二、精細管理水質,創造良好生長環境
水質是水產養殖的核心。在高溫季節,水質管理的重要性更是凸顯。由于水溫較高,水質很容易受到各種因素的影響而迅速惡化。因此,養殖戶需要密切關注池塘的水深和水質變化。
建議將池塘水深保持在1.5米以上,以緩沖高溫對水溫的影響。同時,要定期補水,以保持水質的“肥、活、嫩、爽”。針對夏季容易暴發的藍藻問題,養殖戶更應在藍藻暴發前采取有效措施進行控制和殺滅。
為了維護水質的穩定,定期使用光合細菌、EM菌等微生物制劑是非常必要的。這些制劑能夠促進水體中菌相和藻相的平衡,從而降低氨氮、亞硝酸鹽等有害物質的含量。此外,保證增氧設備的正常運行也是關鍵,特別是在晴天中午和晚上,應提前開啟增氧機,以延長增氧時間,保持水體溶氧充足。
三、全面強化病害防控,降低養殖風險
高溫季節也是羅氏沼蝦病害易發的時期。為了有效防控病害,養殖戶應遵循“預防為主、防治結合”的原則。在高溫季節,盡量減少或避免使用藥物,以降低蝦的應激反應。
為了提高蝦的免疫力,可以定期在飼料中拌入大蒜素、維生素和免疫多糖等添加劑。一旦發現病害,應立即對使用過的器具進行消毒處理,并采取外用消毒或潑灑中藥、內服中西藥物等措施進行控制。在必要時,也可以適時起捕,以*大程度降低損失。
四、加強巡塘管理,確保安全生產
巡塘管理是確保養殖安全的重要環節。養殖戶應堅持早中晚三次巡塘,仔細觀察并記錄羅氏沼蝦的活動情況、攝食情況、體色變化以及水質和天氣的變化情況。通過對這些數據的細致分析可以及時發現并解決問題。
在天氣炎熱、持續高溫的情況下,晚上應加強值班和巡塘。特別是在悶熱的天氣里,要特別注意觀察蝦是否有浮頭現象,以避免因缺氧而導致的泛池現象。此外定期檢修養殖設備和設施也是必不可少的。確保用電安全和其他生產安全,為羅氏沼蝦的健康成長提供有力保障。
總之,夏季高溫季節對于羅氏沼蝦養殖而言是一個不小的挑戰,但只要掌握了科學的管理方法和應對措施就能夠有效降低養殖風險,確保羅氏沼蝦的健康生長和豐收。希望以上分享能夠對廣大養殖戶有所幫助。
聲明:部分內容、圖片、音視頻素材來源于互聯網收集整理,僅供參考,不代表本站對其內容(觀點)正確性的完全認可!如有相關需求,請聯系我們并以具體溝通為準!如內容侵犯了原著者權益,請聯系我們刪除。